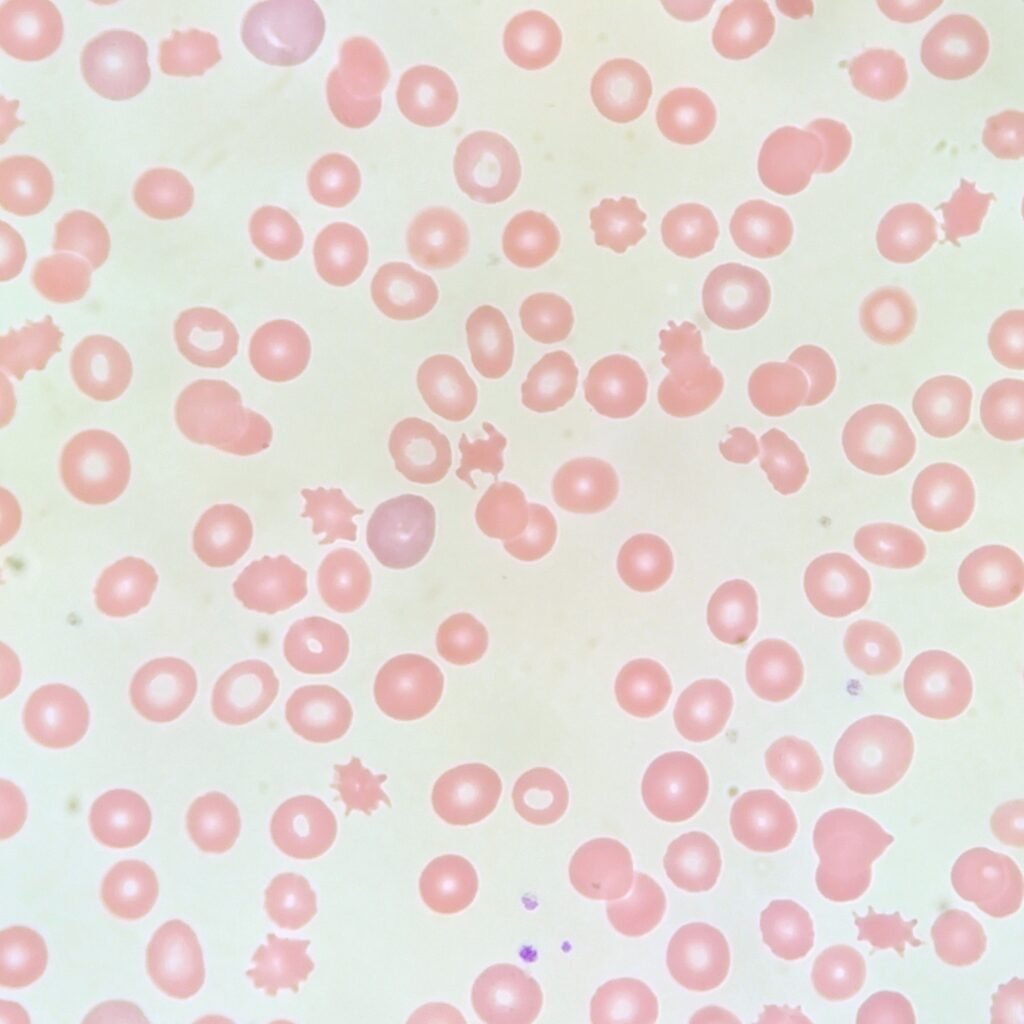
acanthocyte red blood cell morphology

Acanthocytes, also known as spur cells, are clinically significant for severe liver disease, alcoholic cirrhosis, chronic starvation, and abetalipoproteinemia. They form as a result of imbalances between cholesterol and lipid content in the red blood cell’s membrane. In cases of liver disease, excess cholesterol increases the surface area of the red blood cell, causing irregular projections.
Appearance & Identification
On a peripheral blood smear, acanthocytes appear as small, densely staining erythrocytes with several irregular projections. They typically lack central pallor.
Study Tip: The root word “acantha” is Greek for thorn or spine. Remember this and you can remember the morphology!

Lookalikes
Acanthocytes can be confused with burr cells. However, the projections on burr cells are evenly distributed and more numerous. Burr cells also contain central pallor.
Bench Tip: Burr cells are bumpy, Acanthos are funky!
Quick Summary
- Also Known As:
- Spur Cells
- Morphology/Appearance:
- Several irregular projections
- Typically lack central pallor
- Clinical Significance:
- Severe liver disease
- Alcoholic cirrhosis
- Chronic starvation
- Abetalipoproteinemia
- Common Lookalikes
- Burr Cells which have more evenly distributed projections
Acanthocyte Gallery

Related Posts
References
Authored by Rachel Harper, Medical Laboratory Scientist (ASCP)
Last reviewed: January 2026
For educational and reference purposes only, this is not medical advice.













